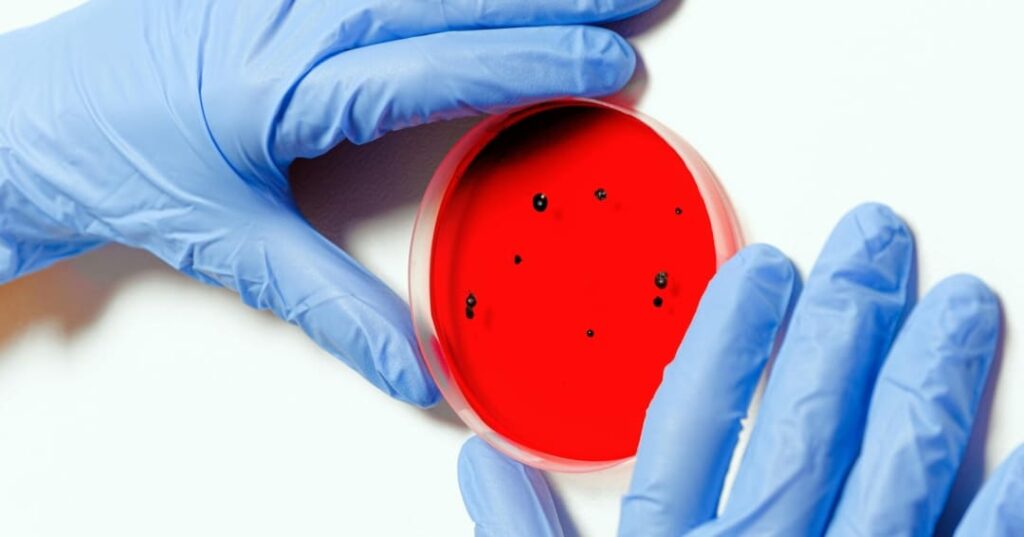
primer antiviral de amplio espectro

Científicos del Centro de Postgrado de la Universidad de la Ciudad de Nueva York en Estados Unidos desarrollan el primer antiviral de amplio espectro, pensado para los virus más poderosos.
Científicos de la Iniciativa de Nanociencia del Centro de Investigación Científica Avanzada del Posgrado de CUNY (CUNY ASRC) han conseguido un importante avance en la lucha contra enfermedades virales. Su investigación abre la posibilidad de crear el primer antiviral de amplio espectro (BSA) del mundo, capaz de combatir diversos virus letales, incluidas posibles amenazas pandémicas futuras.
A diferencia de las infecciones bacterianas, que suelen tratarse de inmediato con antibióticos de amplio espectro mientras se identifica el agente causante, las infecciones virales requieren antivirales específicos, efectivos únicamente frente a un conjunto reducido de virus relacionados.

“Esta falta de tratamientos puede dejar a las poblaciones vulnerables durante años, mientras se desarrollan vacunas y terapias”.
afirmó el investigador principal, Adam Braunschweige.
Los glicanos son clave

El equipo de Braunschweig decidió enfrentar este reto global enfocándose en un rasgo común presente en la superficie de numerosos virus: los glicanos de la envoltura viral, es decir, moléculas de azúcar cuya estructura se mantiene en familias virales distintas.
Pese a ser ampliamente compartidos, estos glicanos no habían sido aprovechados hasta ahora como blanco para el desarrollo de antivirales. En su investigación, los científicos evaluaron 57 receptores sintéticos de carbohidratos (SCR), pequeñas moléculas diseñadas para unirse a dichos glicanos.
De este análisis lograron identificar cuatro compuestos principales que lograron bloquear la infección de siete virus pertenecientes a cinco familias no relacionadas, entre ellos algunos de los más peligrosos conocidos: Ébola, Marburgo, Nipah, Hendra, SARS-CoV-1 y SARS-CoV-2.
En un experimento decisivo, uno de los compuestos principales de SCR se administró a ratones infectados con SARS-CoV-2. El resultado fue que el 90% de los animales tratados sobrevivieron, frente al 0% del grupo de control.
Estudios posteriores confirmaron que la eficacia de estos compuestos radica en su capacidad para unirse a los glicanos de la envoltura viral, un mecanismo de acción innovador que podría tener aplicaciones no solo en el tratamiento de infecciones, sino también en el ámbito del cáncer y de diversas enfermedades inmunológicas.

“Este es el tipo de herramienta antiviral que el mundo necesita con urgencia. Si surge un nuevo virus mañana, actualmente no tenemos nada que implementar. Estos compuestos ofrecen el potencial de ser esa primera línea de defensa”.
afirmó Braunschweig.
La próxima etapa del trabajo del equipo estará orientada a llevar los compuestos más prometedores a la fase de ensayos clínicos.
FUENTE: Science Advances.
IMÁGENES: Pexels.